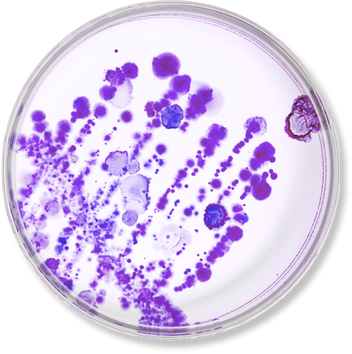

probaskin collagen capsules (ch)
probaskin collagen capsules (ch)
Aktuell sehr beliebt!
Innovative 14-in-1-Formel mit Ovoderm-Kollagen, unterstützt durch einen patentierten Bakterienstamm und wichtige Nährstoffe wie Vitamin A, Biotin, Kupfer und Mangan für eine gesunde Haut.
- Packungsinhalt für 30 Tage
- Kollagen Ovoderm®innovatives, für Vegetarier geeignetes Kollagen
- NU-06 Lactobacillus plantarumPatentierter hitzeinaktivierter Bakterienstamm
Finden Sie Ihre ideale Kollagenform:
Mehr kaufen, mehr sparen!




Verfügbarkeit für Abholungen konnte nicht geladen werden


Bezahlen nach 30 Tagen mit Klarna.
-
Gratis Versand ab € 30
-
Lieferzeit 1-2 Werktage
-
90-Tage-Geld-zurück-Garantie













probaskin collagen capsules (ch)
-
Ohne Tierversuche
-
Ohne Palmöl
-
GVO-frei
-
natürliche Inhaltstoffe
-
Ohne Parabene
-
Apotheken-Qualität
Einklappbarer Inhalt
Inhaltsstoffe
Zutaten: Eierschalenmembran mit 22% Kollagen; Kapselhülle: Hypromellose, Natriumhyaluronsäure; Lactobacillus plantarum NU-06 (tyndallisiert); Magnesium-L-Ascorbat; Füllstoff: Akaziengummi; Astaxanthin; Traubenkernextrakt (Vitis vinifera L.); D-alpha-Tocopherylsäuresuccinat; Ubichinon; Trennmittel: Magnesiumsalze der Speisefettsäuren; L-Selenomethionin; D-Biotin; Retinylpalmitat; Mangancitrat; Riboflavin; Kupfercitrat
Einnahmehinweis
Dosierungsanleitung
Erwachsene nehmen täglich 2 Kapseln vor der Mahlzeit mit einem Glas Wasser ein.
Wichtige Hinweise
Die angegebene empfohlene Tagesdosis darf nicht überschritten werden. Nahrungsergänzungsmittel sind kein Ersatz für eine abwechslungsreiche und ausgewogene Ernährung und eine gesunde Lebensweise. Nicht während der Schwangerschaft oder in der Stillzeit einnehmen.
Klinisch erprobt
-
94%sind mit der Feuchtigkeitsversorgung ihrer Haut zufrieden
Sichtbare Ergebnisse in 2 Monaten
-
94%sind mit der Feuchtigkeitsversorgung ihrer Haut zufrieden
-
12%Mehr Hautelastizität
-
9%Weniger Pigmentierung
Bekannt aus





Unsere sorgfältig ausgewählten Zutaten

Intensivere Wirkung der Hautpflege
Probiotika verbessern die Wirksamkeit anderer Hautpflege-Wirkstoffe, indem sie die Absorptionsfähigkeit des Körpers verbessern.
Durch diese verbesserte Absorption erhält die Haut eine höhere Konzentration an nützlichen Vitaminen, Mineralien und Antioxidantien, die für die Reparatur, die Pflege und den Schutz der Haut von entscheidender Bedeutung sind.
Darüber hinaus sorgt ein gesundes Mikrobiom für eine effizientere Zufuhr dieser Nährstoffe in die Haut, wodurch die Wirkung von Hautpflegeprodukten maximiert wird und die Haut ein gesünderes und strahlenderes Aussehen erhält.
Probiotika wirken also wie ein Katalysator, der die allgemeine Gesundheit und das Aussehen der Haut verbessert.
Das sagen unsere Fachleute

Um mit zunehmendem Alter ein jugendliches Aussehen zu bewahren, müssen wir den optimalen Kollagengehalt in unserem Körper wiederherstellen - den Kollagenabbau rückgängig machen.
Dr. Filip Meersman, FRSC, PhD in Biochemie
Maximale probiotische Wirkung
Patentierter Behälter zur Konservierung der Bakterien: Der doppelwandige Behälter wurde speziell entwickelt, um die wertvollen Inhaltsstoffe vor Feuchtigkeit, Sauerstoff, Licht und Temperaturschwankungen zu schützen und so ihre Wirksamkeit zu bewahren.
Patentiertes Kollagen
Die Kollagenpeptide von OVODERM(R) überstehen teilweise den Verdauungsprozess, ohne aufgespalten zu werden, und haben daher eine verbesserte Bioverfügbarkeit im Körper.
FAQ
-
Wie lange dauert es, bis ich eine Verbesserung spüre?
Die natürliche Regenerationszeit der Haut beträgt 28 Tage. Es kann daher zwei bis drei Wochen dauern, bis eine Verbesserung eintritt. Manche Menschen bemerken jedoch schon nach wenigen Tagen eine deutliche Verbesserung ihrer Haut.
-
Wie lange sollte ich probaskin Kollagenkapseln einnehmen?
Idealerweise sollte die Einnahme von probaskin Kollagenkapseln ein fester Bestandteil der täglichen Hautpflegeroutine werden. Wir empfehlen, nupure probaskin Kollagenkapseln mindestens 3 Monate lang einzunehmen, um der Haut und der Darmflora genügend Zeit zur Regeneration zu geben.
-
Sind probaskin Kollagenkapseln für Vegetarier geeignet?
Ja, das innovative Ovoderm-Kollagen wird aus der Eierschalenmembran gewonnen und ist somit auch für Vegetarier geeignet. Die Kapseln sind auf pflanzlicher Basis hergestellt und frei von Gelatine.
-
Warum enthalten nupure probaskin Kollagenkapseln so viele Nährstoffe?
Das Aussehen und die allgemeine Gesundheit der Haut hängen in hohem Maße von einer ausreichenden Versorgung mit verschiedenen Vitaminen, Mineralien und Spurenelementen ab. Kollagenkapseln von nupure probaskin unterstützen die Haut mit einer sorgfältig ausgewählten Nährstoffmischung.

Wie können wir Ihnen helfen?
-
E-Mail an info@nupureshop.com
-
Anruf unter +49 (0)8276 5187790
Bleiben Sie auf dem Laufenden
Exklusive Sonderangebote, Produkteinführungen sowie die neuesten wissenschaftlichen Erkenntnisse stets in Ihrem Posteingang.